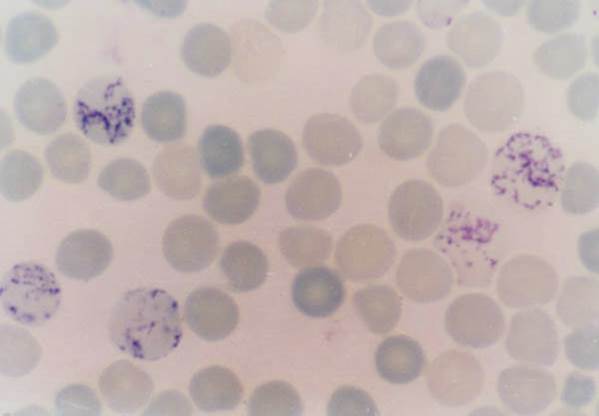

正文
红细胞(erythrocyte, red blood cell )直径约7.5μm , 其大小较为均一,有时可作为估计其它细胞或结构大小的“内标尺”。红细胞呈双凹圆盘状,表面光滑,中央较薄,约0.75μm,周边较厚,约2.6μm(图4-2)。在血涂片标本上显示,中央染色较浅、周边染色较深。这一形态结构特点与体积相同的球形结构相比表面积增大约25%,还一可使细胞内任何一点距细胞表面的距离缩短至0.85μm以下,再加上胞质内大量的血红蛋白,最大限度地增强了气体交换的功能。
成熟红细胞是结构功能高度特化的细胞,无细胞核,也无细胞器,细胞内充满了血红蛋白.
红细胞内的主要成分是血红蛋白(hemoglobin, hb ),血红蛋白是含叶琳铁的蛋白质,约占红细胞重量的33%,它易与酸性染料结合,染成橘红色。当血液流经肺脏时,由于肺泡内o2分压高,co2分压低,血红蛋白即释放co2与o2结合,形成氧合血红蛋白;相反,当血液流经其他器官组织时,由于这些器官组织内co2分压高,o2分压低,血红蛋白释放所带的o2并结合co2,形成氨基甲酸血红蛋白。血红蛋白这一特点是红细胞在体内完成气体运输和交换功能的化学基础。
单个红细胞在新鲜时为淡黄绿色,大量红细胞使血液呈猩红色。在大的血管,红细胞常松散地黏附在一起,成缗钱状(图4-2,c)。红细胞有一定的弹性和形态可变性,它能通过自身的变形而顺利通过直径更小的毛细血管。红细胞正常形态的维持需足够的atp供能以及细胞内、外渗透压的平衡。当缺乏atp供能时可使其形态由圆盘状变为棘球状,当atp供能状态改善后亦可恢复。当血浆渗透压降低时导致血浆液体进人红细胞内,细胞肿胀呈球形甚至破裂,称溶血(hemolysis ),残留的红细胞膜囊称血影(ghost);若血浆渗透压升高,红细胞内水分析出胞外,致使红细胞皱缩严重,也可导致膜破坏而溶血。

(图4-2红细胞形态。 a图:扫描电镜图加上颜色后显示红细胞的双凹圆盘状。x1800; b图标注红细胞的大小;c图为小血管中的红细胞,可见红细胞缗钱,并估计该处血管管径约为15um)。he,x250.
红细胞的胞膜内面由多种蛋白组成,其中主要有血影蛋白(spectrin)和肌动蛋白。这些蛋白形成一层网状支架,锚定在细胞膜下,使红细胞保持双凹圆盘状,或随环境改变而变形。红细胞的质膜上有血型抗原h、血型抗原a和(或)血型抗原b,它们均为膜糖蛋白。根据血型抗原在膜上的有无,大致可将人血型分为a型、b型、o型和ab型四型。
血流中还可见少量尚未完全成熟的红细胞,用煌焦油蓝染色可见胞质内有染成蓝色的细网或颗粒,称为网织红细胞〔reticulocyte )(图4-3)。这些细网和颗粒是红细胞在成熟的过程中,残留在胞质内的部分核糖体,说明该细胞仍有合成血红蛋白的功能。网织红细胞进人外周血1-3天后,核糖体等细胞器消失,成为成熟红细胞。成年人外周血中网织红细胞占红细胞总数的0.5% - 1%,新生儿可达3%一6%。在骨髓造血功能发生障碍的患者,经治疗后网织红细胞计数增加,表示骨髓造血功能增强。
(图4-3人血涂片示网织红细胞 (煌焦油蓝染色))
红细胞的平均寿命约120天、衰老的红细胞在脾、肝和骨髓等处被巨噬细胞吞噬。其血红蛋白中的铁可被重新利用造血。